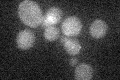
YJR044C
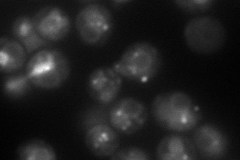
YJR044C
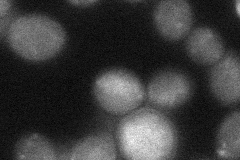
YJR044C
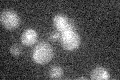
YJR044C

View description
Late endosomal protein involved in late endosome to vacuole trafficking; functional homolog of human obesity receptor gene-related protein (OB-RGRP)
Localization:
Intensity:
Fold change:
Significance:
-
C’ GFP library in SD
below threshold18.47 -
N' NOP1pr-GFP in SD
punctate,vacuole membrane87.6079 -
N' TEF2pr-mCherry in SD

ER,vacuole182.895 -
N' NATIVEpr-GFP in SD

punctate34.6547 -
N' TEF2pr-VC and Cyto-VN in SD
below threshold29.3038 -
C’ GFP library in SD+DTT

cytosol17.60.95No -
C’ GFP library in SD+H2O2

cytosol15.450.83No -
C’ GFP library in Starvation Media
cytosol14.870.8No -
C’ GFP library on the background of Pup2-DaMP

below threshold -
C’ GFP library on the background of CCT mutant

below threshold15.80290.854975No
